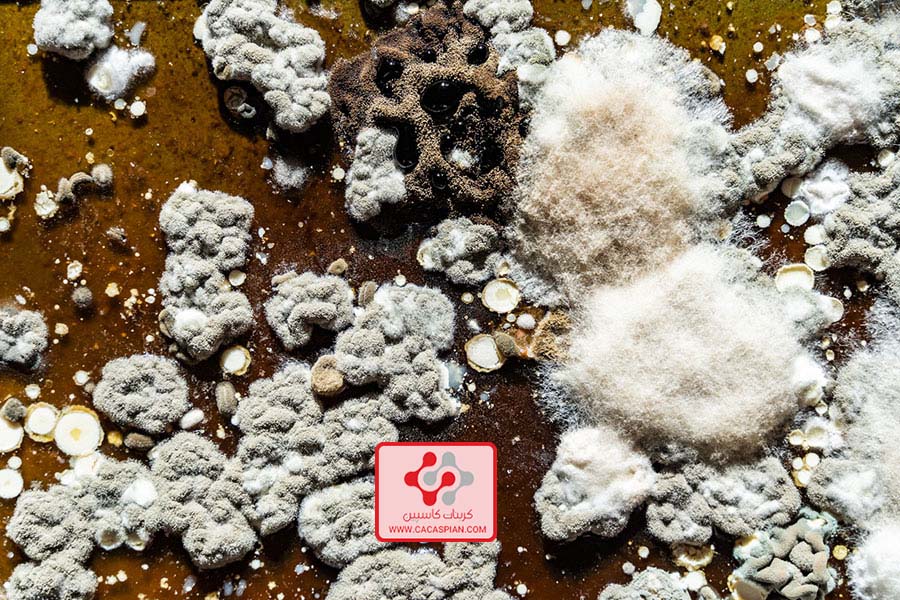

در این مقاله، به بررسی خواص آهک هیدراته، روش های تهیه، کاربردها و روند بازار خرید و فروش آهک هیدراته می پردازیم.
در ابتدا باید به مراحل تهیه آهک هیدراته اشاره کنیم. آهک هیدراته از طریق واکنش آهک زنده با آب به دست می آید. در این واکنش، آهک زنده یا همان کلسیم اکسید به همراه آب بخار ترکیب می شوند و از آنجا که این واکنش قوی و واکنش پذیر است، انرژی زیادی تولید می شود و گازی به نام گاز آبی را به صورت شدیدی ترکیب می کند. این گاز آبی به صورت حباب های بزرگ و فوران کننده از خود نشان می دهد. بعد از این واکنش، ماده ای به نام آهک هیدراته به دست می آید.
 فرمول شیمیایی آهک هیدراته
فرمول شیمیایی آهک هیدراته
آهک هیدراته دارای فرمول شیمیایی هیدروکسید کلسیم است که به صورت Ca(OH)2 نمایش داده می شود. این ماده حالت پودری دارد و به رنگ سفید است. خاصیت شیمیایی آهک هیدراته شامل واکنش پذیری با دیگر مواد است. به طور معمول، آهک هیدراته با دیگر مواد شیمیایی واکنش می دهد و ترکیبات جدیدی تشکیل می شود. این خاصیت آن را برای استفاده در صنایع مختلف بسیار مفید می کند.
کاربردهای مهم آهک هیدراته در صنعت ساختمان
یکی از کاربردهای مهم آهک هیدراته در صنعت ساختمان است. در این صنعت، آهک هیدراته به عنوان یک ماده حاکم بر تنش ها و تغییرات حجمی استفاده می شود. این خواص آن را برای استفاده در ساخت سیمان و بتن مناسب می کند. آهک هیدراته همچنین در تولید کاشی و سرامیک و همچنین در صنعت کاغذ و مقوا به عنوان کلسیم منبع استفاده می شود.
آهک هیدراته در صنعت آهن و فولاد و پتروشیمی
علاوه بر صنعت ساختمان، آهک هیدراته نقش مهمی در صنعت آهن و فولاد و پتروشیمی نیز دارد. در صنعت آهن و فولاد، آهک هیدراته به عنوان یک ماده تقویت کننده استفاده می شود و در فرایندهای صنعتی مختلف برای بهبود کیفیت و خواص فولاد استفاده می شود. در صنعت پتروشیمی نیز، آهک هیدراته به عنوان ماده ای معادل استفاده می شود و در تولید محصولات شیمیایی مهم استفاده می شود.
فروش اهک هیدراته در مجموعه cacaspian
فروش اهک هیدراته درکاسپین با کیفیت و خلوص بی نظیر صورت می گیرد. متخصصان ما در شرکت کاسپین آماده همکاری با شما هستند تا به صورت حرفهای و با دقت بالا، کیفیت محصول خریداری شده را تضمین کنند. همچنین، ما آمادگی داریم به صورت گسترده فروش اهک هیدراته را در کشور انجام دهیم. برای خرید و کسب اطلاعات بیشتر، با ما تماس بگیرید.
تولید آهک هیدراته
تولید آهک هیدراته برای استفاده در صنایع مختلف از جمله صنایع سیمان، شیشه سازی، شیمیایی و غیره بسیار مهم است. فرآیند تولید آهک هیدراته از مراحل زیر تشکیل میشود:
1- تهیه آهک پخته: در این مرحله، کربنات کلسیمی که به عنوان خام مورد استفاده قرار میگیرد را در یک کوره پخت میکنند. در این فرآیند کربنات کلسیم تبدیل به اکسید کلسیم (آهک پخته) میشود.
2- هیدراسیون آهک پخته: پس از تهیه آهک پخته، آن را با آب ترکیب میکنند. در این مرحله آب به آهک پخته اضافه شده و اکسید کلسیم با آب واکنش میدهد تا هیدروکسید کلسیم (آهک هیدراته) تشکیل شود.
3- شکستن و خرد کردن آهک هیدراته: در این مرحله، آهک هیدراته دستکاری شده را به اندازههای مورد نیاز برای استفاده در صنایع مختلف خرد میکنند، مانند آهک هیدراته پودری یا خردههای کوچک.
در نهایت، آهک هیدراته آماده استفاده در صنایع مختلف میشود. تولید آهک هیدراته از دستگاه هیدراسیون باعث کاهش خلوص و افزایش کیفیت آهک میشود. این دستگاه با استفاده از بخار آب داغ و فشار اقدام به شکفته کردن آهک پخته میکند و در نتیجه آهک هیدراته تولید میشود.
مصارف آهک هیدراته در زمینه های مختلف وکاربرد ها
 صنعت فولادسازی
صنعت فولادسازی
آهک هیدراته به عنوان یک ذخیره انرژی مورد استفاده قرار میگیرد. آهک هیدراته با استفاده از خاصیت جذب حرارتی خود، در فرایند تولید فولاد انرژی لازم برای آب زنی و تبدیل سنگ آهن به آهن خام فراهم می کند. در صنعت فولاد نیز از آهک هیدراته به عنوان یک ماده حفاظتی برای پوشش دهی کوره های فولادی استفاده می شود. آهک هیدراته باعث کاهش سرعت اکسیداسیون فولاد در دمای بالا می شود و بهبود مقاومت آن را افزایش می دهد.
صنایع ساختمانی
آهک هیدراته در تولید مصالح ساختمانی مانند سیمان و بتن استفاده می شود. این ماده باعث تشکیل یک چسبندگی قوی بین سنگ ها و دیگر مواد در مصالح ساختمانی می شود و استحکام و پایداری آنها را افزایش می دهد. همچنین، در صنعت ساختمانی نیز از آهک هیدراته استفاده می شود. این ماده به عنوان یک مایع اصلاح کننده خاک و پایدار کننده در مخلوط های خاکی استفاده می شود. همچنین، در تهیه بتن و سیمان نیز از آهک هیدراته استفاده می شود.
صنایع شیمیایی
آهک هیدراته در تولید محصولات شیمیایی مانند لاستیک، پلاستیک، رزین و صنعت روغن استفاده می شود. این ماده به عنوان یک عامل نرم کننده و پایدار کننده در ترکیبات شیمیایی عمل می کند. در صنایع شیمیایی نیز از آهک هیدراته به عنوان یک ماده حفظ کننده و چسبندگی استفاده می شود. این ماده به عنوان یک حفظ کننده PH در فرآیندهای شیمیایی استفاده می شود و همچنین بهبود خواص چسبندگی مواد شیمیایی را نیز دارد.
کشاورزی
آهک هیدراته برای تنظیم pH خاک و کاهش اسیدیته خاک استفاده می شود. با تنظیم pH خاک به حالت مطلوب، میزان جذب عناصر غذایی برای گیاهان افزایش پیدا می کند و عملکرد آنها را بهبود می بخشد.
صنایع نساجی
آهک هیدراته در فرآیند رنگرزی الیاف نساجی استفاده می شود. این ماده در تثبیت رنگ در الیاف نساجی نقش دارد و باعث پایداری و مقاومت بیشتر رنگ در برابر شستشو می شود.
صنعت کاغذسازی
 آهک هیدراته در تولید کاغذ به عنوان یک عامل فعال کننده استفاده می شود. این ماده باعث افزایش کیفیت کاغذ و جلوگیری از پوسیدگی و تیرگی آن می شود. همچنین، در صنایع کاغذ سازی، آهک هیدراته برای کنترل pH و افزایش استحکام کاغذ استفاده می شود. این ماده کمک می کند تا کاغذ مناسب برای چاپ و نگهداری شود و خاصیت خورندگی آن را کاهش می دهد.
آهک هیدراته در تولید کاغذ به عنوان یک عامل فعال کننده استفاده می شود. این ماده باعث افزایش کیفیت کاغذ و جلوگیری از پوسیدگی و تیرگی آن می شود. همچنین، در صنایع کاغذ سازی، آهک هیدراته برای کنترل pH و افزایش استحکام کاغذ استفاده می شود. این ماده کمک می کند تا کاغذ مناسب برای چاپ و نگهداری شود و خاصیت خورندگی آن را کاهش می دهد.
آهک هیدراته علاوه بر کاربردهای صنعتی، در برخی مصارف دیگر نیز استفاده می شود. برخی از کاربردهای آهک هیدراته عبارتند از
مصارف دیگر: آهک هیدراته در صنایع دیگری مانند تولید گچ، کاشی و سرامیک، پنچره و شیشه سازی و تولید کارتن نیز به کار می رود.
کاربرد های آهک هیدراته به صورت گسترده ای در صنایع مختلف استفاده می شود. یکی از کاربردها این است که در صنعت تولید کاشی و سرامیک به عنوان یک ماده افزودنی استفاده می شود. آهک هیدراته باعث افزایش لمینتاسیون و سفیدی کاشی می شود و همچنین بهبود مقاومت آن را نیز افزایش می دهد.
قیمت آهک هیدراته
با توجه به اطلاعات موجود، قیمت آهک هیدراته معمولاً در بازار داخلی و خارجی متغیر است و به عوامل متعددی بستگی دارد. به عنوان مثال:
- خلوص محصول: آهک هیدراته با درصدهای مختلفی از کلسیم هیدروکسید به بازار عرضه می شود. خلوص بالاتر معمولاً با قیمت بیشتری همراه است.
- میزان سفارش: حجم سفارش و مقداری که نیاز دارید نیز می تواند بر قیمت تأثیر بگذارد. عموماً حجم سفارش بزرگتر به قیمت تخفیف می دهد.
- نوع بسته بندی: بسته بندی آهک هیدراته نیز می تواند تأثیری در قیمت داشته باشد. بسته بندی های کوچکتر معمولاً هزینه بسته بندی و حمل و نقل بیشتری را نیاز دارد و ممکن است قیمت را بالا ببرد.
- محل تحویل: محل تحویل نیز می تواند در قیمت تأثیر گذار باشد. هزینه های حمل و نقل و وقوع قوانین مربوط به حمل و نقل ممکن است با توجه به محل تحویل متفاوت باشد.
- مصارف داخلی یا صادراتی: آهک هیدراته ممکن است برای استفاده در داخل کشور یا برای صادرات به کشورهای دیگر بوده و بسته به اینکه برای چه منطقه یا بازاری استفاده می شود، قیمت متفاوتی داشته باشد.
به عنوان نمونه قیمت آهک هیدراته در بازار داخلی ایران به تومان معمولاً هر تن به صورت توافقی در بازه 1,000,000 تا 2,000,000 تومان قرار می گیرد. البته برای دسترسی به قیمت دقیق و بروز می توانید با بخش بازرگانی گروه کاسپین تماس بگیرید.
روش های انبار نمودن آهک هیدراته
1- حفظ خشکی: برای جلوگیری از تماس آهک هیدراته با رطوبت هوا و جذب آب، بهتر است آن را در محیط خشک نگهدارید. محل انبار باید خنک و خشک باشد تا از رطوبت جلوگیری شود.
2- بسته بندی مناسب: آهک هیدراته را باید به صورت بسته بندی شده نگهداری کنید. از کیسه ها و بسته بندی مناسب برای جلوگیری از تماس مستقیم با آب ورودی به دستگاه و خرده شدن آهک هیدراته استفاده کنید.
3- حفاظت از ضربات فیزیکی: کیسه ها را محافظت کنید و از ضربات فیزیکی محافظت نمایید. از طریق استفاده از پالت یا روکش های محافظ، می توانید از آسیب دیدن کیسه ها جلوگیری کنید.
4– جداگانه از مواد واکنش دهنده انبار کنید: آهک هیدراته یک ماده قابل تحلیل و تعامل با مواد دیگر است. بنابراین، آن را به دور از مواد چربی، اسیدها و مواد دیگری که ممکن است با آهک واکنش داشته باشند، نگهداری کنید.
5– توانایی تهویه: برای جلوگیری از تجمع بخار آب و اکسیداسیون آهک هیدراته، به تهویه مناسب در محیط انباری توجه کنید. مطمئن شوید که هوا به طور منظم تجدید شود تا هوا تازه و خشک باشد.
 سخن اخر
سخن اخر
در نهایت، علاوه بر روش های فوق، بهتر است دستورالعمل های تامین ایمنی و نگهداری سازندگان آهک هیدراته را مرور و رعایت کنید. همچنین، در صورت نیاز به اطلاعات بیشتر، می توانید با تولید کننده یا متخصصان cacaspian.com مشورت کنید.
در آخرین قسمت از این مقاله، به روند بازار خرید و فروش آهک هیدراته پرداختیم. به طور کلی، بازار آهک هیدراته به دلیل استفاده گسترده این ماده در صنایع مختلف به خوبی تقاضا و عرضه را تامین می کند. قیمت آهک هیدراته بسته به فاکتورهایی مانند کیفیت، حجم خرید و نوع استفاده متغیر است. اما به طور کلی، قیمت آهک هیدراته در بازار معمولا پایدار است و افزایش ناچیزی دارد.
به طور خلاصه، خرید آهک هیدراته در صنایع مختلف بسیار مهم و ضروری است. بازار خرید و فروش آهک هیدراته پایدار است و قیمت آن به دلیل عوامل مختلف تغییرات کمی دارد.



 فرمول شیمیایی آهک هیدراته
فرمول شیمیایی آهک هیدراته  صنعت فولادسازی
صنعت فولادسازی سخن اخر
سخن اخر

